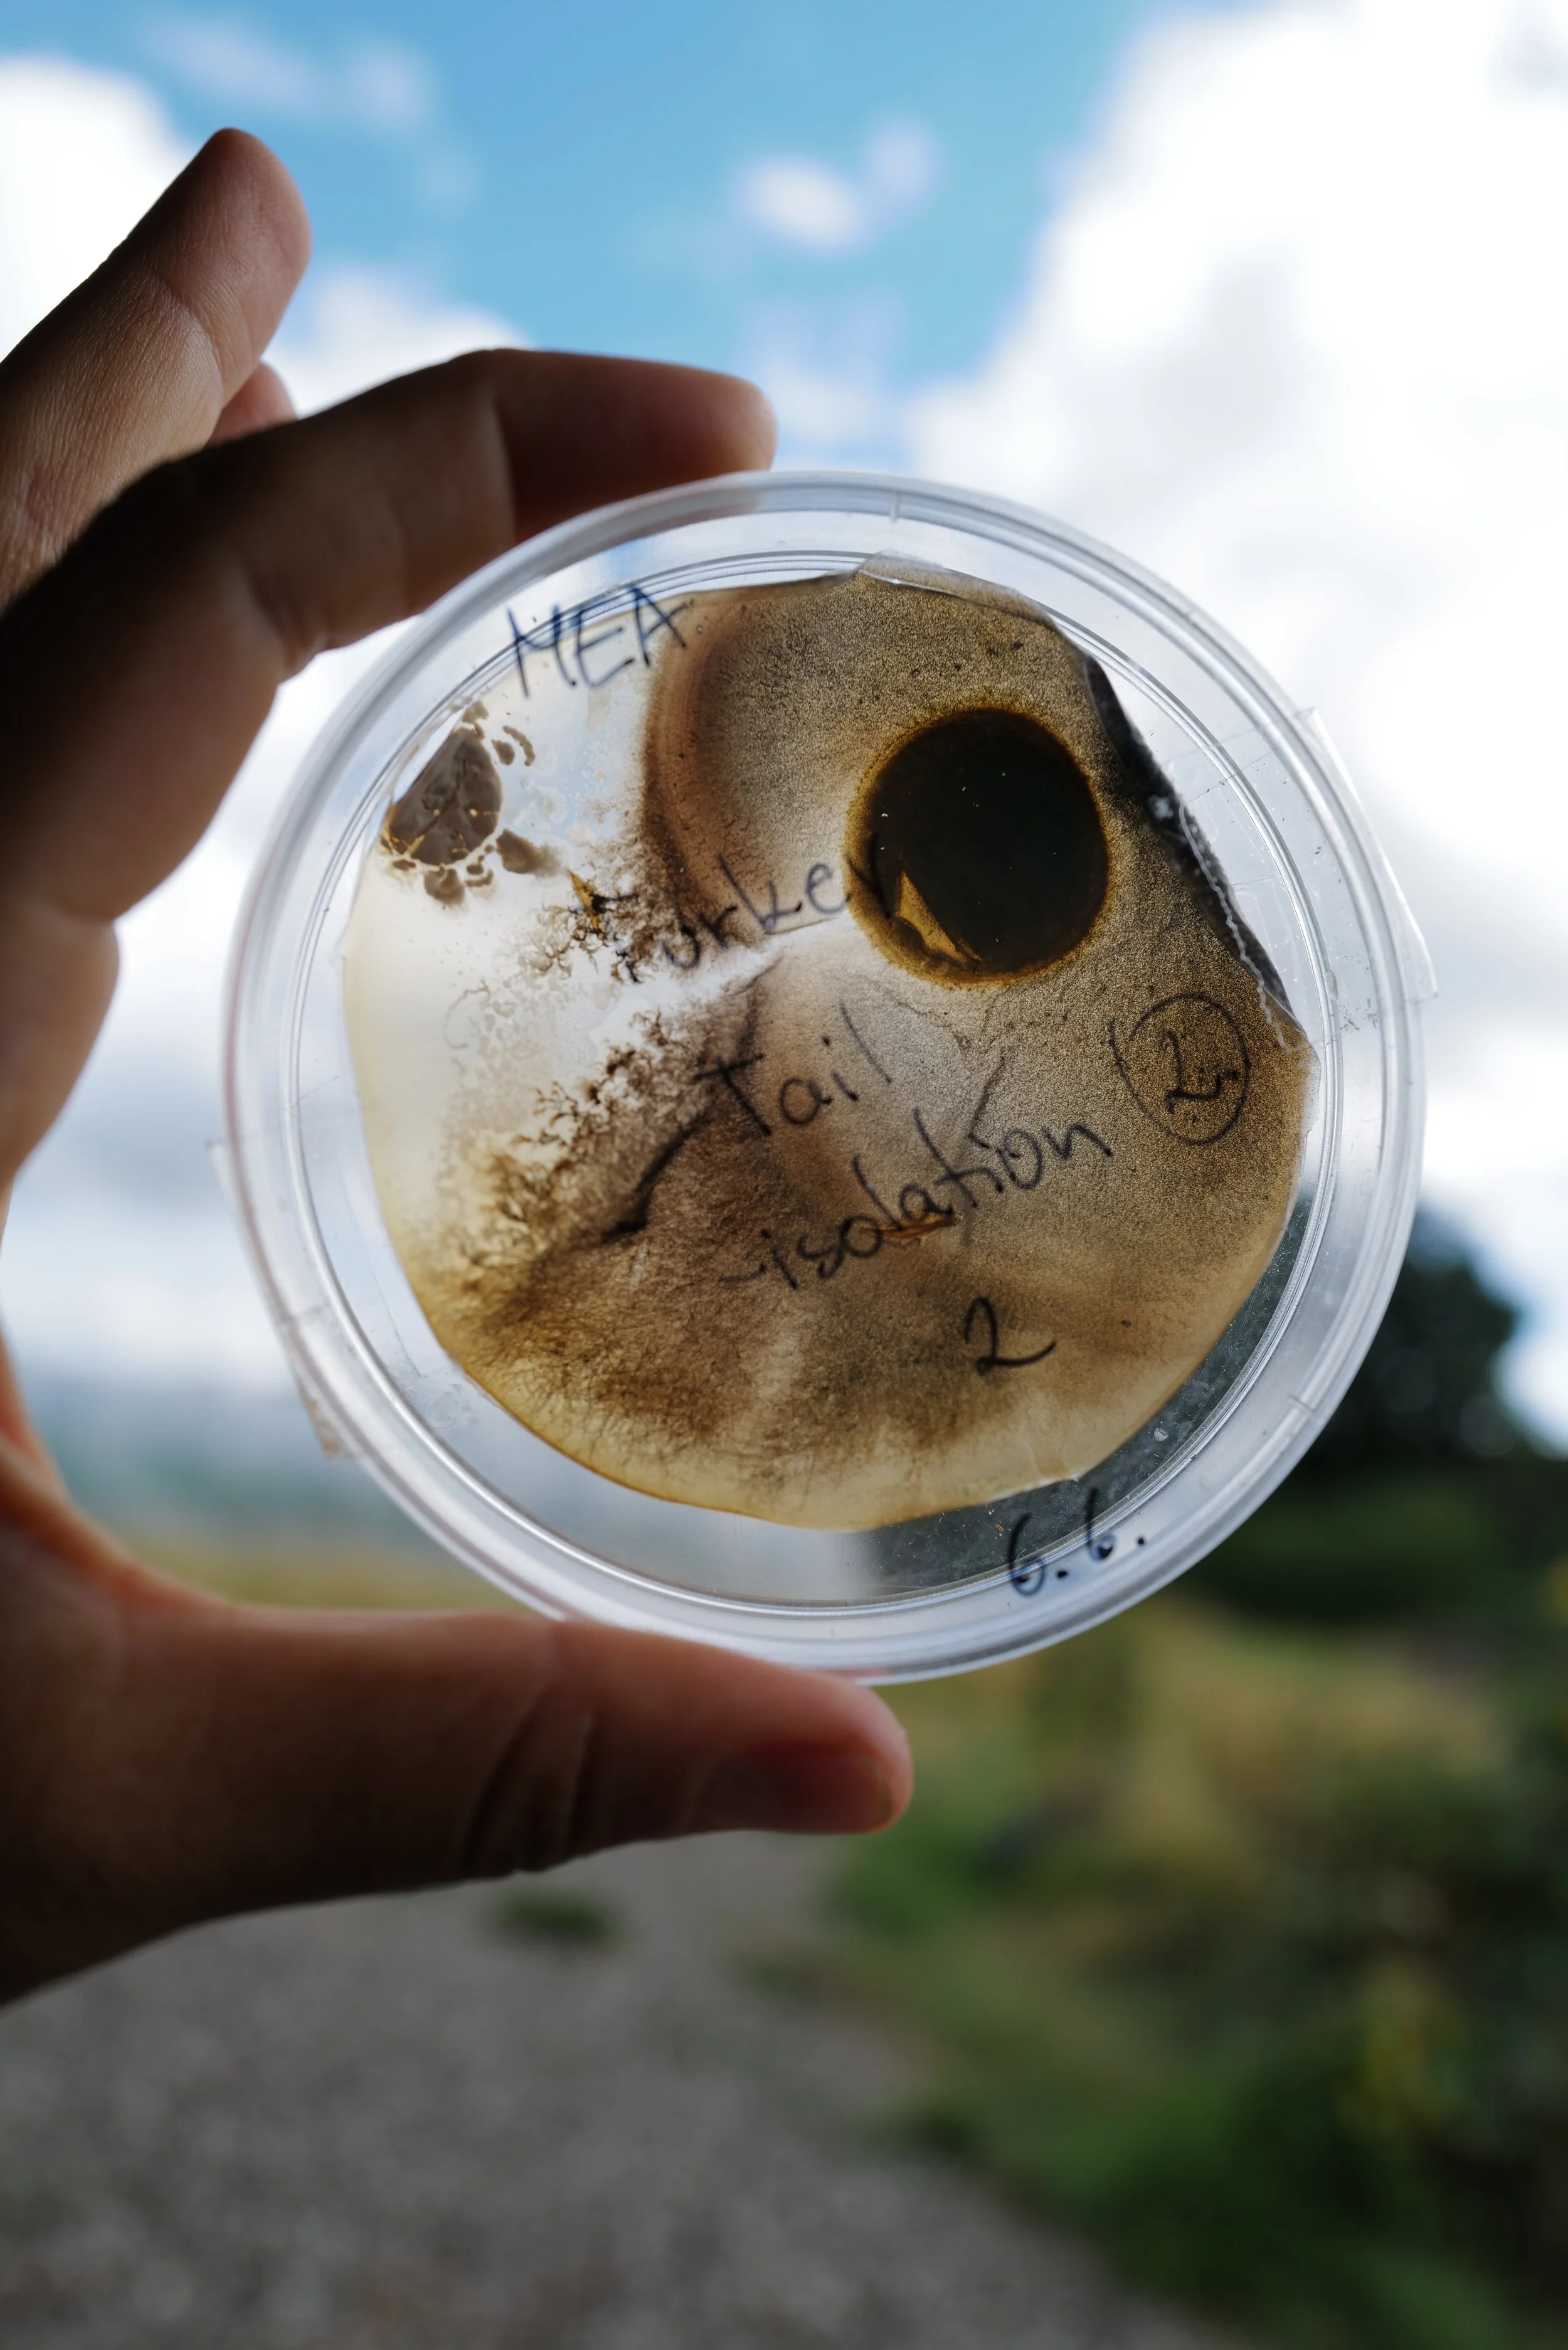

Fungi
Academy
FUNGI ACADEMY
Youth led, fungi-fuelled futures.
We created the UK’s first AQA-certified programme in Mushroom Cultivation & Mycology, created to empower young people facing barriers to education and employment.
We deliver fungi education through dynamic, creative sessions that offer engaging alternatives for young people to engage with nature AND receive an AQA accreditation in the process. Here, students explore fungi as a tool for climate action, regenerative world-building and social innovation.
We combine science and agriculture with imagination and creativity - teaching cultivation, sustainable systems, outdoor practical work and future-forward thinking. Championing a generation of young innovators who see fungi not just as food - but as living technology for a better world.
We cultivate mushrooms with our young people and sell fresh harvests to the local community.
We run outreach mushroom-growing workshops and events with local youth groups and community centres across the borough and on the GROW Farm.


MUSHROOM CULTIVATION AQA COURSES
What? A creative lab where students explore fungi as a tool for climate action, world-building, and social innovation.
Who? 13-18 year olds.
Where? The GROW Farm, The Totteridge Academy, OR at external site.

GET INVOLVED
Want to learn more or stay up-to-date with GROW Mushroom Academy? Whether you’re keen to:
Join a course
Buy our mushrooms
Collaborate on a project
Or support our work
Contact lotta@wearegrow.org or…
Big shout to Mycopunks for sponsoring & supplying us with cultivation materials!